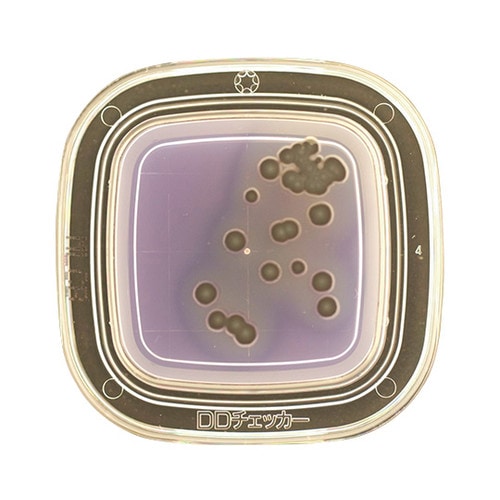
【冷蔵】04270 MLCB寒天 20枚×2

培地関連用品の売れ筋ランキング
- ¥6,030(税込) (税込)
- ¥3,135(税込) (税込)
- ¥2,090(税込) (税込)
商品の特徴 |
食品・環境の衛生管理を目的に細菌を容易・確実・迅速に検出。 |
|---|---|
商品仕様 |
|
メーカー情報 |
|
カタログ掲載ページ |
-/- |
| 注意事項 | ※この商品は貯蔵または配送の際に冷蔵が必要な商品です。 |
|---|